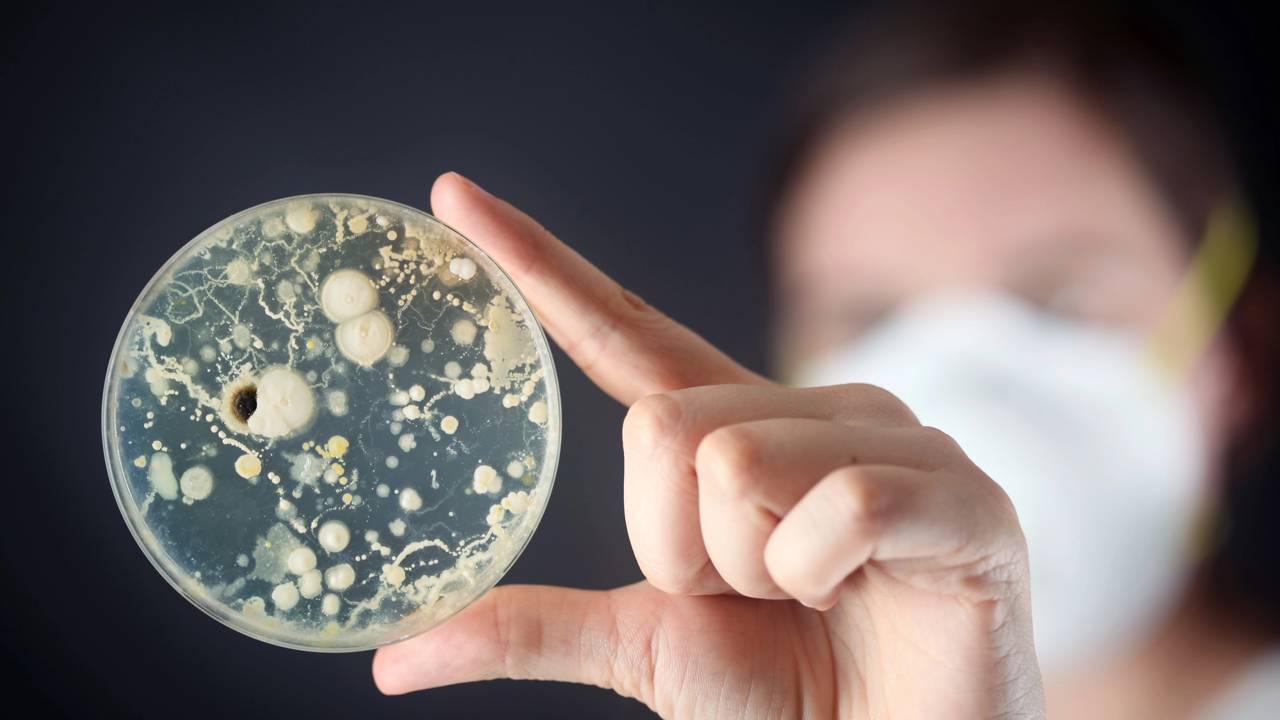
A bactéria que resistiu às salas limpas da NASA e reacendeu o alerta de contaminação planetária

Há também outros concursos com oportunidades em vários cargos. E destinadas a candidatos de todos os níveis de escolaridade.
Clique aqui para conferir a lista completa de concursos disponíveis nesta semana e com inscrições abertas nos próximos dias.
Confira as oportunidades
Veja abaixo a lista de cargos selecionados pelo UOL, considerando os maiores salários e número de vagas.
TJ-CE (Tribunal de Justiça do Ceará) - Vagas: 30 / Escolaridade: superior / Salário: R$ 35.877,27 / Inscrições: até 22/5 / Mais informações aqui
PGE-PI (Procuradoria-Geral do Estado do Piauí) - Vagas: 10 / Escolaridade: superior / Salário: R$ 32.319,67 / Inscrições: até 2/6 / Mais informações aqui
Prefeitura de Lençóis Paulista (SP) - Vagas: 2 / Escolaridade: médio e superior / Salário: de R$ 2.004,69 até R$ 21.886,25 / Inscrições: até 6/5 / Mais informações aqui
Brigada Militar-RS - Vagas: 120 / Escolaridade: superior / Salário: R$ 21.513,44 / Inscrições: até 5/5 / Mais informações aqui
Brigada Militar-RS - Vagas: 30 / Escolaridade: superior / Salário: R$ 21.513,44 / Inscrições: até 7/5 / Mais informações aqui
Prefeitura de Paranavaí (PR) - Vagas: 89 / Escolaridade: fundamental, médio, técnico e superior / Salário: de R$ 1.518 até R$ 20.634,38 / Inscrições: até 25/5 / Mais informações aqui
Pré-Sal Petróleo/RJ - Vagas: 100 / Escolaridade: superior / Salário: de R$ 8.240 até R$ 19.610 / Inscrições: até 14/5 / Mais informações aqui
Tribunal Marítimo/RJ - Vagas: 1 / Escolaridade: superior / Salário: R$ 18.484,54 / Inscrições: até 13/5 / Mais informações aqui
TRT-2 (Tribunal Regional do Trabalho de São Paulo) - Vagas: 2 / Escolaridade: superior / Salário: de R$ 9.052,51 até R$ 17.018,67 / Inscrições: até 22/5 / Mais informações aqui
Prefeitura de Florianópolis (SC) - Vagas: 6 / Escolaridade: superior / Salário: R$ 16.977,58 / Inscrições: até 19/5 / Mais informações aqui
Câmara de Praia Grande (SP) - Vagas: 6 / Escolaridade: técnico e superior / Salário: de R$ 4.432,30 até R$ 16.413,82 / Inscrições: até 15/5 / Mais informações aqui
Prefeitura de Tianguá (CE) - Vagas: 408 / Escolaridade: fundamental, médio, técnico e superior / Salário: de R$ 1.518 até R$ 15.812,50 / Inscrições: até 8/5 / Mais informações aqui
USP (Universidade de São Paulo) - Vagas: 5 / Escolaridade: superior / Salário: de R$ 6.819,65 até R$ 15.498,97 / Inscrições: até 2/7 / Mais informações aqui
Prefeitura de Itapirapuã Paulista (SP) - Vagas: 33 / Escolaridade: fundamental, médio, técnico e superior / Salário: de R$ 1.587,22 até R$ 15 mil / Inscrições: de 12/5 até 26/5 / Mais informações aqui
TRE-TO (Tribunal Regional Eleitoral do Tocantins) - Vagas: 4 / Escolaridade: superior / Salário: de R$ 9.052,51 até R$ 14.852,66 / Inscrições: até 9/5 / Mais informações aqui
TRF4 (Tribunal Regional Federal da 4ª Região - PR, SC e RS) - Vagas: não definido / Escolaridade: superior / Salário: de R$ 9.052,51 até R$ 14.852,66 / Inscrições: até 14/5 / Mais informações aqui
FCRB (Fundação Casa de Rui Barbosa)/RJ - Vagas: 10 / Escolaridade: superior / Salário: de R$ 7.710,83 até R$ 14.579,91 / Inscrições: até 12/5 / Mais informações aqui
PM-PR (Polícia Militar do Paraná) - Vagas: 90 / Escolaridade: superior / Salário: de R$ 4.629,60 até R$ 14.366,35 / Inscrições: até 9/6 / Mais informações aqui
Crea-RS (Conselho Regional de Engenharia e Agronomia do Rio Grande do Sul) - Vagas: 44 / Escolaridade: médio e superior / Salário: de R$ 3.331,23 até R$ 13.662 / Inscrições: até 8/5 / Mais informações aqui
Prefeitura de Serrania (MG) - Vagas: 47 / Escolaridade: fundamental, médio, técnico e superior / Salário: de R$ 1.352 até R$ 13.401,70 / Inscrições: de 19/5 até 23/6 / Mais informações aqui
Prefeitura de Niterói (RJ) - Vagas: 69 / Escolaridade: médio, técnico e superior / Salário: de R$ 2.932,97 até R$ 12.903,03 / Inscrições: até 22/5 / Mais informações aqui
ION (Empresa de Infraestrutura e Obras de Niterói)/RJ - Vagas: 58 / Escolaridade: médio, técnico e superior / Salário: de R$ 2.300,40 até R$ 12.002 / Inscrições: até 12/5 / Mais informações aqui
Prefeitura de Belo Horizonte (MG) - Vagas: 582 / Escolaridade: médio e superior / Salário: de R$ 1.908,77 até R$ 11.747,78 / Inscrições: de 2/6 até 2/7 / Mais informações aqui
CRC-SP (Conselho Regional de Contabilidade do Estado de São Paulo) - Vagas: 365 / Escolaridade: médio e superior / Salário: de R$ 4.011 até R$ 11.683 / Inscrições: até 5/6 / Mais informações aqui
Prefeitura de Itatiba (SP) - Vagas: 286 / Escolaridade: fundamental, médio, técnico e superior / Salário: de R$ 1.518 até R$ 11.631,72 / Inscrições: até 15/5 / Mais informações aqui
Câmara de Piedade (SP) - Vagas: não definido / Escolaridade: fundamental, médio e superior / Salário: de R$ 2.840,62 até R$ 11.132,41 / Inscrições: até 15/5 / Mais informações aqui
PF (Polícia Federal) - Vagas: 192 / Escolaridade: médio e superior / Salário: de R$ 7.444,80 até R$ 11.070,93 / Inscrições: até 21/5 / Mais informações aqui
UFABC (Universidade Federal do ABC)/SP - Vagas: 10 / Escolaridade: superior / Salário: R$ 10.481,64 / Inscrições: até 30/5 / Mais informações aqui
Prefeitura de São Vicente (SP) - Vagas: 276 / Escolaridade: médio, técnico e superior / Salário: de R$ 2.688,19 até R$ 10.224,30 / Inscrições: até 28/5 / Mais informações aqui
Prefeitura de Jundiaí (SP) - Vagas: 2 / Escolaridade: superior / Salário: de R$ 9.085,57 até R$ 9.765,95 / Inscrições: de 12/5 até 16/6 / Mais informações aqui
Emparn (Empresa de Pesquisa Agropecuária do Rio Grande do Norte) - Vagas: 16 / Escolaridade: médio e superior / Salário: de R$ 2.184,38 até R$ 9.714,41 / Inscrições: até 8/5 / Mais informações aqui
Consórcio Intermunicipal de Saúde 8 de Abril/SP - Vagas: 41 / Escolaridade: fundamental, médio, técnico e superior / Salário: de R$ 1.518 até R$ 9.680,38 / Inscrições: até 26/5 / Mais informações aqui
Prefeitura de Vermelho Novo (MG) - Vagas: 74 / Escolaridade: fundamental, médio, técnico e superior / Salário: de R$ 1.723,93 até R$ 9.541,32 / Inscrições: de 30/6 até 31/7 / Mais informações aqui
Marinha - Vagas: 174 / Escolaridade: superior / Salário: R$ 9.070,60 / Inscrições: até 14/5 / Mais informações aqui
Marinha - Vagas: 25 / Escolaridade: superior / Salário: R$ 9.070,60 / Inscrições: até 12/5 / Mais informações aqui
Prefeitura de Santana de Parnaíba (SP) - Vagas: 49 / Escolaridade: alfabetizado, médio e superior / Salário: de R$ 1.572,20 até R$ 8.991,47 / Inscrições: até 15/5 / Mais informações aqui
TJM-SP (Tribunal de Justiça Militar do Estado de São Paulo) - Vagas: 4 / Escolaridade: médio e superior / Salário: de R$ 7.552,65 até R$ 8.514,27 / Inscrições: de 9/5 até 9/6 / Mais informações aqui
Prefeitura de Joinville (SC) - Vagas (temporárias): não definido / Escolaridade: fundamental, médio, técnico e superior / Salário: de R$ 2.131,09 até R$ 8.492,46 / Inscrições: até 5/5 / Mais informações aqui
MP-PI (Ministério Público do Piauí) - Vagas: 30 / Escolaridade: médio e superior / Salário: de R$ 5.407,39 até R$ 8.388,73 / Inscrições: até 23/5 / Mais informações aqui
Câmara de Angatuba (SP) - Vagas: 3 / Escolaridade: superior / Salário: R$ 8.359,14 / Inscrições: até 19/5 / Mais informações aqui
Exército - Vagas: 231 / Escolaridade: superior / Salário: de R$ 7.490 até R$ 8.245 / Inscrições: até 20/6 / Mais informações aqui
Conab (Companhia Nacional de Abastecimento) - Vagas: 403 / Escolaridade: médio e superior / Salário: de R$ 3.459,87 até R$ 8.140,88 / Inscrições: até 15/5 / Mais informações aqui
Marinha - Vagas: 66 / Escolaridade: médio / Salário: de R$ 1.500 até R$ 7.500 / Inscrições: até 12/5 / Mais informações aqui
Exército - Vagas: 440 / Escolaridade: médio / Salário: de R$ 1.200 até R$ 7.500 / Inscrições: até 9/5 / Mais informações aqui
Prefeitura de Campinas (SP) - Vagas: 40 / Escolaridade: fundamental e superior / Salário: de R$ 2.321,76 até R$ 7.481,28 / Inscrições: de 12/5 até 23/6 / Mais informações aqui
Prefeitura de Osasco (SP) - Vagas (temporárias): 131 / Escolaridade: fundamental, médio, técnico e superior / Salário: de R$ 1.589,80 até R$ 7.214,80 / Inscrições: até 22/5 / Mais informações aqui
Prefeitura de Francisco Morato (SP) - Vagas: 28 / Escolaridade: fundamental, médio, técnico e superior / Salário: de R$ 1.985,98 até R$ 7.159,78 / Inscrições: até 12/5 / Mais informações aqui
Prefeitura de Capivari (SP) - Vagas: 43 / Escolaridade: fundamental, médio, técnico e superior / Salário: de R$ 2.275,76 até R$ 7.109,01 / Inscrições: até 20/5 / Mais informações aqui
Seduc-MT (Secretaria de Educação de Mato Grosso) - Vagas: 1.500 / Escolaridade: superior / Salário: de R$ 3.671,84 até R$ 7.005,09 / Inscrições: até 8/5 / Mais informações aqui
SEE-PB (Secretaria da Educação da Paraíba) - Vagas: 2.000 / Escolaridade: superior / Salário: R$ 6.944,09 / Inscrições: até 8/5 / Mais informações aqui
PC-CE (Polícia Civil do Ceará) - Vagas: 750 / Escolaridade: superior / Salário: R$ 6.732,71 / Inscrições: até 16/5 / Mais informações aqui
Prefeitura de Nova Castilho (SP) - Vagas: 14 / Escolaridade: fundamental, médio e superior / Salário: de R$ 1.822,26 até R$ 6.479,36 / Inscrições: até 13/5 / Mais informações aqui
Marinha - Vagas: 32 / Escolaridade: médio / Salário: R$ 6.387,75 / Inscrições: até 16/5 / Mais informações aqui
Cremese-SE (Conselho Regional de Medicina de Sergipe) - Vagas: 110 / Escolaridade: médio e superior / Salário: de R$ 2.887,58 até R$ 6.275,81 / Inscrições: até 20/6 / Mais informações aqui
IFRN (Instituto Federal de Educação, Ciência e Tecnologia do Rio Grande do Norte) - Vagas: 52 / Escolaridade: superior / Salário: R$ 6.180,86 / Inscrições: até 3/6 / Mais informações aqui
PM-PR (Polícia Militar do Paraná) - Vagas: 2.000 / Escolaridade: superior / Salário: R$ 6.101,87 / Inscrições: até 13/5 / Mais informações aqui
Corpo de Bombeiros do Paraná - Vagas: 600 / Escolaridade: superior / Salário: R$ 6.101,87 / Inscrições: até 13/5 / Mais informações aqui
Corpo de Bombeiros do Ceará - Vagas: 1.350 / Escolaridade: médio / Salário: R$ 5.893,30 / Inscrições: de 14/5 até 2/6 / Mais informações aqui
Crefito-MA (Conselho Regional de Fisioterapia e Terapia Ocupacional do Maranhão - 16ª Região) - Vagas: 5 / Escolaridade: médio e superior / Salário: de R$ 2.000 até R$ 5.850 / Inscrições: até 12/5 / Mais informações aqui
PM-CE (Polícia Militar do Ceará) - Vagas: 1.500 / Escolaridade: médio / Salário: de R$ 2.773,35 até R$ 5.568,64 / Inscrições: até 12/5 / Mais informações aqui
Prefeitura de Monteiro Lobato (SP) - Vagas: 6 / Escolaridade: médio, técnico e superior / Salário: de R$ 2.159,09 até R$ 5.355,84 / Inscrições: até 9/5 / Mais informações aqui
Prefeitura de Ipaussu (SP) - Vagas: 59 / Escolaridade: fundamental, médio e superior / Salário: de R$ 1.826 até R$ 5.253 / Inscrições: até 11/5 / Mais informações aqui
Prefeitura de Igarassu (PE) - Vagas: 398 / Escolaridade: médio e superior / Salário: de R$ 3.655,26 até R$ 5.200 / Inscrições: até 12/5 / Mais informações aqui
Idema-RN (Instituto de Desenvolvimento Sustentável e Meio Ambiente do Rio Grande do Norte) - Vagas: 180 / Escolaridade: superior / Salário: R$ 5.118,52 / Inscrições: até 6/6 / Mais informações aqui
Instituto Butantan/SP - Vagas: 11 / Escolaridade: superior / Salário: R$ 5.037,04 / Inscrições: até 23/5 / Mais informações aqui
UFMG (Universidade Federal de Minas Gerais) - Vagas: 22 / Escolaridade: médio e superior / Salário: de R$ 3.029,90 até R$ 4.967,04 / Inscrições: até 26/5 / Mais informações aqui
UFMS (Universidade Federal de Mato Grosso do Sul) - Vagas: 48 / Escolaridade: médio, técnico e superior / Salário: de R$ 3.029,90 até R$ 4.967,04 / Inscrições: até 25/5 / Mais informações aqui
Prefeitura de Guarujá (SP) - Vagas (temporárias): 1.092 / Escolaridade: médio, técnico e superior / Salário: de R$ 1.754,39 até R$ 4.941,19 / Inscrições: até 12/5 / Mais informações aqui
Ufam (Universidade Federal do Amazonas) - Vagas: 74 / Escolaridade: superior / Salário: de R$ 2.437,59 até R$ 4.875,18 / Inscrições: de 12/5 até 13/6 / Mais informações aqui
PM-SP (Polícia Militar de São Paulo) - Vagas: 165 / Escolaridade: médio / Salário: R$ 4.833,27 / Inscrições: até 2/6 / Mais informações aqui
Fundação Juquery (Fundação Estatal Regional de Saúde e Desenvolvimento Social da Bacia do Juquery), em Franco da Rocha (SP) - Vagas: 88 / Escolaridade: médio, técnico e superior / Salário: de R$ 1.650 até R$ 4.605,39 / Inscrições: até 7/5 / Mais informações aqui
Câmara de Viçosa (MG) - Vagas: 13 / Escolaridade: médio e superior / Salário: de R$ 3.082,25 até R$ 4.587,63 / Inscrições: de 12/6 até 14/7 / Mais informações aqui
SEE-PE (Secretaria de Educação e Esportes de Pernambuco) - Vagas (temporárias): 725 / Escolaridade: médio e superior / Salário: de R$ 2.229,42 até R$ 4.580,57 / Inscrições: até 11/5 / Mais informações aqui
Prefeitura de João Pessoa (PB) - Vagas: 403 / Escolaridade: superior / Salário: de R$ 1.946,79 até R$ 4.567,31 / Inscrições: até 14/5 / Mais informações aqui
UFPR (Universidade Federal do Paraná) - Vagas: 25 / Escolaridade: técnico e superior / Salário: de R$ 2.667,19 até R$ 4.556,92 / Inscrições: até 13/5 / Mais informações aqui
Prefeitura de Flores de Goiás (GO) - Vagas: 666 / Escolaridade: fundamental, médio, técnico e superior / Salário: de R$ 1.518 até R$ 4.384 / Inscrições: até 21/5 / Mais informações aqui
Câmara de Mariana (MG) - Vagas: 15 / Escolaridade: médio, técnico e superior / Salário: de R$ 2.287,32 até R$ 4.269,52 / Inscrições: até 8/5 / Mais informações aqui
Câmara de Platina (SP) - Vagas: 1 / Escolaridade: superior / Salário: R$ 4.107,77 / Inscrições: até 5/5 / Mais informações aqui
CRO-AC (Conselho Regional de Odontologia do Acre) - Vagas: 390 / Escolaridade: médio, técnico e superior / Salário: de R$ 1.684,78 até R$ 4.011 / Inscrições: até 5/6 / Mais informações aqui
Exército - Vagas: 1.125 / Escolaridade: médio / Salário: de R$ 1.500 até R$ 4.000 / Inscrições: até 18/5 / Mais informações aqui
CRMV-PE (Conselho Regional de Medicina Veterinária de Pernambuco) - Vagas: 105 / Escolaridade: médio, técnico e superior / Salário: de R$ 1.518 até R$ 4.000 / Inscrições: até 5/5 / Mais informações aqui
Uerj (Universidade do Estado do Rio de Janeiro) - Vagas: 11 / Escolaridade: médio e técnico / Salário: de R$ 3.112,91 até R$ 3.771,18 / Inscrições: até 4/5 / Mais informações aqui
Guarda Municipal de Duque de Caxias (RJ) - Vagas: 500 / Escolaridade: médio / Salário: R$ 2.912,50 / Inscrições: até 12/5 / Mais informações aqui
Prefeitura de Jenipapo dos Vieiras (MA) - Vagas: 216 / Escolaridade: fundamental, médio e superior / Salário: de R$ 1.518 até R$ 2.895,19 / Inscrições: até 28/5 / Mais informações aqui
Prefeitura de Belford Roxo (RJ) - Vagas: 1.723 / Escolaridade: médio e superior / Salário: de R$ 1.518 até R$ 2.300 / Inscrições: até 9/6 / Mais informações aqui
Marinha - Vagas: 153 / Escolaridade: fundamental / Salário: R$ 1.398,30 / Inscrições: até 8/5 / Mais informações aqui

German (DE)
English (US)
Spanish (ES)
French (FR)
Hindi (IN)
Italian (IT)
Portuguese (BR)
Russian (RU)
6 meses atrás
14

:strip_icc()/i.s3.glbimg.com/v1/AUTH_59edd422c0c84a879bd37670ae4f538a/internal_photos/bs/2023/l/g/UvNZinRh2puy1SCdeg8w/cb1b14f2-970b-4f5c-a175-75a6c34ef729.jpg)










Comentários
Aproveite ao máximo as notícias fazendo login
Entrar Registro